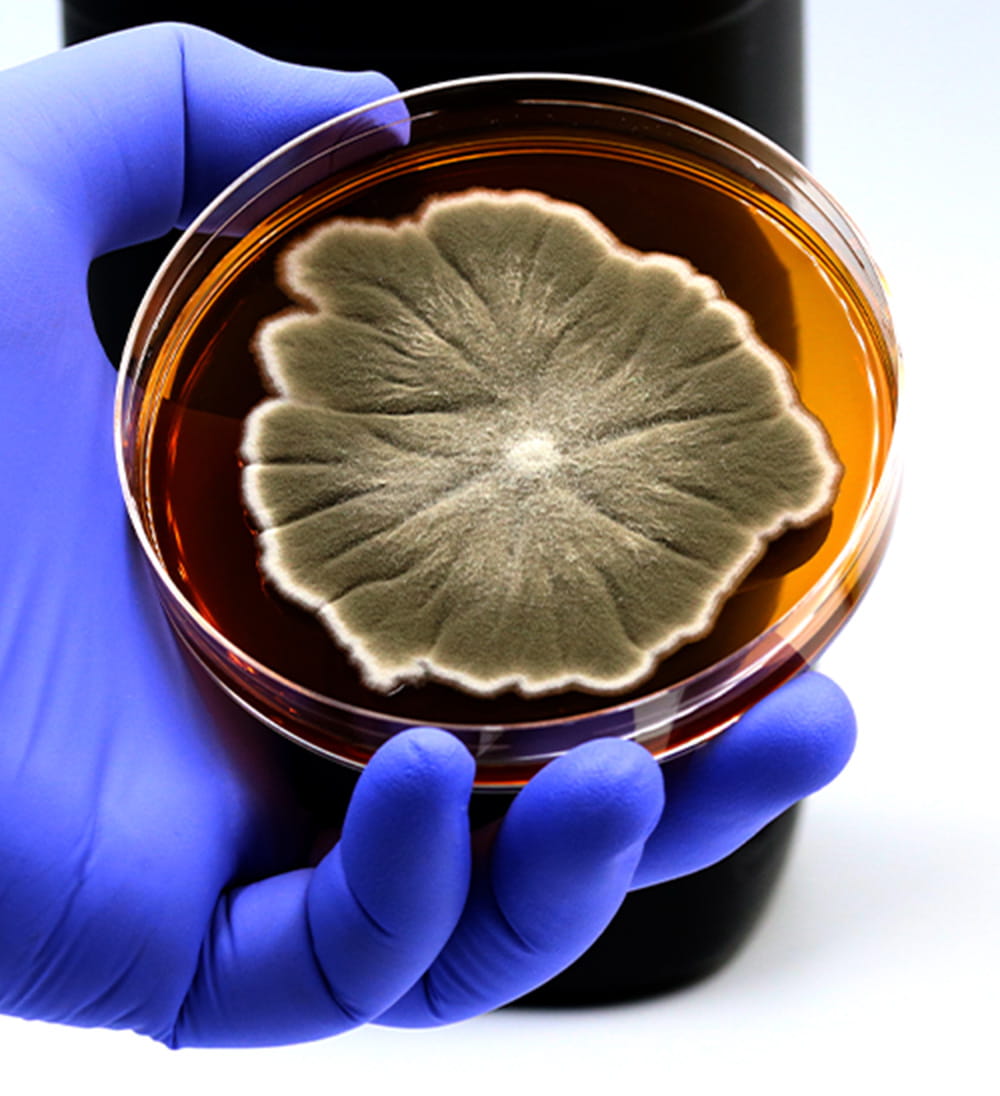

Houston Methodist Division of Allergy & Immunology
The Houston Methodist Division of Allergy & Immunology provides comprehensive care for patients with allergies and immunologic diseases, ranging from environmental allergies, drug and food allergies, urticaria and angioedema, allergic asthma, atopic dermatitis and systematic inflammatory conditions, to immune deficiency disorders. Our board-certified allergists and immunologists identify, study and treat complex allergic and immune disorders that often go undiscovered elsewhere.
We fulfill our mission to improve patients’ quality of life through innovative research science and the highest clinical expertise. We lead immunologic medicine through this research and by training immunologists to continue the advancement of this field for future generations.
Our locally and nationally respected experts collaborate to achieve accurate diagnosis and successful treatment of complicated immunologic conditions. This team-based approach fosters information sharing, with joint projects underway to uncover and understand mutual disease mechanisms and origins.
23
Our Team
Our physician-scientists and clinicians treat patients across the full spectrum of immunologic and allergic subspecialties. Leveraging access to the most advanced medical technology and research resources available through the Texas Medical Center, we apply a team-based approach to evidence-based allergy and immunology medicine for the Greater Houston community.
Houston Methodist fosters faculty and clinician achievement through the support for research and education, collaboration and career development, intramural seed funding, extramural funding support, and a variety of other resources and services.
Division chair David Huston, MD, is the Deputy Editor for the Journal of Allergy and Clinical Immunology, the #1 cited journal in this discipline.
Our award-winning faculty have received recognition for their groundbreaking research. Tina Motazedi, MD, was a 2024 recipient of the American Board of Medical Specialists Visiting Scholar Award.
Our Faculty ➝
Our Research
We advance medicine through the study of complex and orphaned immunological conditions, with robust findings published in peer-reviewed journals. Our physician-scientists work in state-of-the-art facilities, and collaborate with investigators in the Houston Methodist Research Institute.
Development of the Houston Methodist Immunology Center has expanded local access to immunologic expertise, minimizing the need for patients to travel for diagnosis and treatment. The research scientists at the Center also conduct clinical trials for immunologic, allergic and autoimmune disease treatments.
Education & Training
Houston Methodist’s Immunology Center strives toward a vibrant future for highly skilled clinicians, groundbreaking research and clinical trials. Our faculty mentors prioritize our medical students and residents through ongoing expanded academic offerings, including the development of an Allergy and Immunology Fellowship and collaboration with Texas A&M University College of Medicine.
Currently, our team trains medical students during clinical rotations and teaches residents in allergy or immunology electives for the Internal Medicine Residency. Residents gain extensive experience with clinical service, quality improvement and clinical research, contributing to committees and peer-reviewed research publications.
Our team brings the next generation of allergists and immunologists the knowledge they’ve acquired through extensive clinical practice. Rather than rote repetition of existing practices, our faculty mentors are passionate about the creation of new evidence-based treatments. Monthly internal training meetings further develop the team collectively and individually, ensuring continuous growth.
Through the Immunology Center, we extend our reach outside our doors by conducting extensive community engagement with Immunology and You symposia.

For Patients
Through our expansive network of hospitals, Houston Methodist provides comprehensive care for patients with immunologic, allergic or autoimmune conditions of any type or complexity.
Division of Allergy & Immunology
Houston Methodist Hospital
6550 Fannin St., Smith Tower
Suite 1101
Houston, TX 77030
713.790.3992